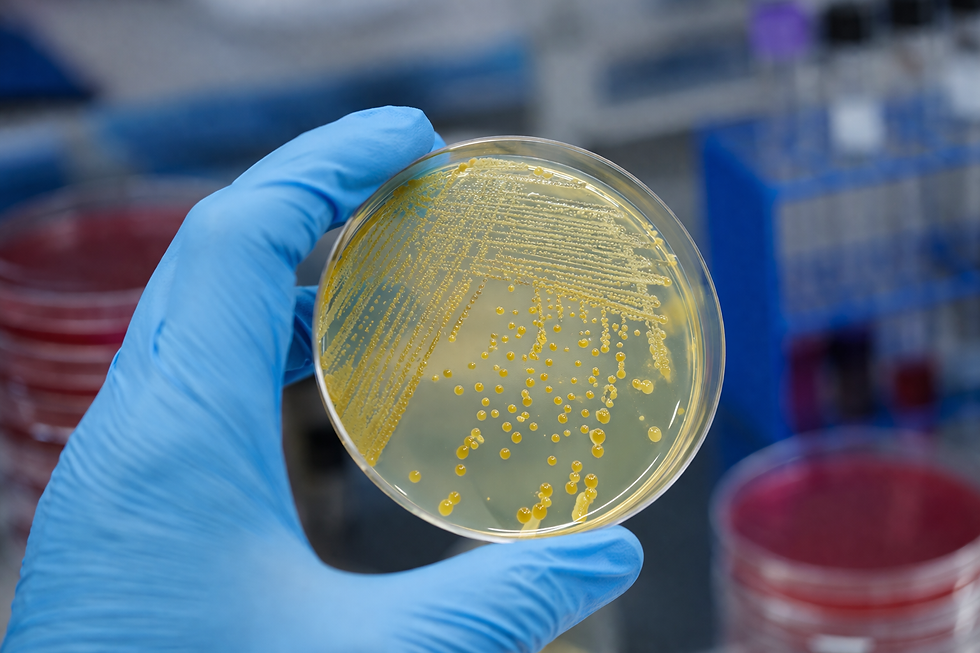

Enterotoxinas estafilocócicas: como surgem e por que são perigosas mesmo após o cozimento
- Keller Dantara
- 14 de mar.
- 7 min de leitura
Introdução
As doenças transmitidas por alimentos (DTAs) continuam sendo um dos principais desafios de saúde pública em escala global, afetando tanto países em desenvolvimento quanto economias industrializadas. Entre os diversos agentes etiológicos envolvidos nesses quadros, destaca-se o Staphylococcus aureus, uma bactéria amplamente distribuída no ambiente e frequentemente associada à microbiota da pele e mucosas humanas. Embora muitas infecções por esse microrganismo estejam relacionadas a processos cutâneos ou hospitalares, sua relevância na área de segurança alimentar decorre, sobretudo, da produção de enterotoxinas termoestáveis.
As enterotoxinas estafilocócicas representam um risco singular: diferentemente de muitos patógenos alimentares, cuja eliminação pode ser alcançada por meio de tratamento térmico adequado, essas toxinas permanecem biologicamente ativas mesmo após processos de cocção convencionais. Isso significa que alimentos aparentemente seguros, submetidos a aquecimento suficiente para eliminar bactérias viáveis, ainda podem causar intoxicações graves caso contenham essas moléculas previamente formadas.
O impacto desse fenômeno é particularmente relevante em ambientes institucionais e industriais, como cozinhas industriais, hospitais, escolas, restaurantes e linhas de produção alimentícia. Falhas na manipulação, armazenamento inadequado e contaminação cruzada são fatores críticos que favorecem a produção dessas toxinas antes do preparo térmico, tornando o controle preventivo a principal estratégia de mitigação de risco.
Este artigo tem como objetivo analisar, de forma aprofundada, a origem, os mecanismos de ação e os riscos associados às enterotoxinas estafilocócicas, com ênfase em sua resistência térmica e implicações para a segurança dos alimentos. Serão abordados o contexto histórico e os fundamentos teóricos, a importância científica e aplicações práticas no setor produtivo, as metodologias analíticas disponíveis e, por fim, as perspectivas futuras para controle e monitoramento desse importante agente de risco.
Contexto Histórico e Fundamentos Teóricos
A associação entre Staphylococcus aureus e intoxicações alimentares foi estabelecida no início do século XX, quando surtos de origem desconhecida passaram a ser investigados em ambientes coletivos. Em 1914, estudos pioneiros já sugeriam que certas cepas bacterianas poderiam produzir substâncias responsáveis pelos sintomas, independentemente da presença de células viáveis no alimento consumido. Esse conceito foi consolidado ao longo das décadas seguintes, culminando na identificação das chamadas enterotoxinas estafilocócicas (SEs – Staphylococcal Enterotoxins).
Classificação e diversidade das enterotoxinas
Atualmente, são conhecidas mais de 20 enterotoxinas estafilocócicas, classificadas de SEA a SEU, com base em diferenças estruturais e antigênicas. Dentre elas, as mais frequentemente associadas a surtos alimentares são SEA, SEB, SEC, SED e SEE. Essas toxinas pertencem à família das superantígenos, moléculas capazes de ativar de forma intensa e não específica o sistema imunológico.
Mecanismo de ação
O efeito patogênico das enterotoxinas estafilocócicas está diretamente relacionado à sua capacidade de atuar como superantígenos. Diferentemente dos antígenos convencionais, que ativam uma pequena fração de linfócitos T, essas toxinas promovem uma ativação maciça dessas células, desencadeando uma liberação exacerbada de citocinas.
Esse fenômeno resulta em sintomas característicos de intoxicação alimentar, como:
Náuseas intensas
Vômitos abruptos
Cólicas abdominais
Diarreia (em menor frequência)
O período de incubação é geralmente curto, variando entre 1 e 6 horas, o que reforça a natureza toxigênica — e não infecciosa — do quadro clínico.
Resistência térmica e estabilidade
Um dos aspectos mais críticos dessas toxinas é sua elevada resistência térmica. Estudos demonstram que muitas enterotoxinas estafilocócicas resistem a temperaturas superiores a 100 °C por períodos prolongados. Isso se deve à sua estrutura proteica altamente estável, com ligações que dificultam a desnaturação térmica.
Além da resistência ao calor, essas toxinas também apresentam estabilidade em diferentes faixas de pH e resistência parcial à ação de enzimas digestivas, o que contribui para sua persistência no trato gastrointestinal após ingestão.
Condições para produção de toxinas
A produção de enterotoxinas pelo S. aureus depende de condições específicas, incluindo:
Temperatura entre 20 °C e 40 °C
pH neutro a levemente ácido
Atividade de água elevada
Presença de nutrientes disponíveis
Alimentos ricos em proteínas e manipulados com frequência — como carnes, laticínios, cremes e produtos de confeitaria — são particularmente suscetíveis.
Normas e regulamentações
No Brasil, a Agência Nacional de Vigilância Sanitária (ANVISA) estabelece critérios microbiológicos para alimentos por meio da RDC nº 331/2019, complementada pela Instrução Normativa nº 161/2022. Embora essas normas foquem na contagem de Staphylococcus coagulase positiva, a presença elevada desse microrganismo é considerada um indicativo de risco potencial para produção de enterotoxinas.
Em âmbito internacional, organismos como a FDA (Food and Drug Administration) e a EFSA (European Food Safety Authority) também reconhecem as enterotoxinas estafilocócicas como importantes agentes de DTAs, reforçando a necessidade de controle preventivo ao longo da cadeia produtiva.
Importância Científica e Aplicações Práticas
A relevância das enterotoxinas estafilocócicas transcende o campo da microbiologia básica, impactando diretamente setores industriais, regulatórios e de saúde pública.
Impacto na indústria alimentícia
Na indústria de alimentos, surtos associados a enterotoxinas estafilocócicas representam riscos significativos, incluindo:
Recall de produtos
Danos à reputação da marca
Prejuízos financeiros
Responsabilização legal
Casos documentados frequentemente envolvem alimentos manipulados manualmente e mantidos em temperaturas inadequadas antes do consumo.
Exemplos de alimentos de risco
Diversos alimentos já foram associados a surtos, incluindo:
Saladas com maionese
Produtos de panificação com recheios cremosos
Carnes cozidas e fatiadas
Leite e derivados
Esses alimentos compartilham características como alta manipulação e condições favoráveis ao crescimento bacteriano antes do consumo.
Estudo de caso
Um estudo conduzido pela EFSA identificou que cerca de 10% dos surtos de intoxicação alimentar na União Europeia estavam relacionados a toxinas bacterianas, com predominância de enterotoxinas estafilocócicas. Em muitos casos, os alimentos haviam sido submetidos a aquecimento, reforçando o papel crítico da toxina pré-formada.
Segurança alimentar e boas práticas
A principal estratégia de controle não é a eliminação da toxina — o que é tecnicamente difícil —, mas a prevenção de sua formação. Isso envolve:
Controle rigoroso de temperatura (cadeia fria)
Redução do tempo de exposição em temperatura ambiente
Higiene adequada dos manipuladores
Uso de equipamentos sanitizados
Implementação de sistemas HACCP (Análise de Perigos e Pontos Críticos de Controle)
Relevância em ambientes institucionais
Hospitais, escolas e cozinhas industriais são ambientes particularmente sensíveis, pois atendem populações vulneráveis. A ingestão de enterotoxinas pode ter consequências mais severas nesses grupos, incluindo desidratação e complicações clínicas.
Metodologias de Análise
A detecção de enterotoxinas estafilocócicas é um desafio analítico relevante, pois envolve a identificação de proteínas em matrizes alimentares complexas.
Métodos microbiológicos indiretos
Tradicionalmente, a análise inicia-se com a quantificação de Staphylococcus coagulase positiva, utilizando meios seletivos como o ágar Baird-Parker. Valores elevados sugerem potencial produção de toxinas, mas não confirmam sua presença.
Métodos imunológicos
Os ensaios imunológicos são amplamente utilizados para detecção direta de enterotoxinas, incluindo:
ELISA (Enzyme-Linked Immunosorbent Assay)
Kits comerciais validados pela AOAC
Esses métodos são sensíveis, relativamente rápidos e específicos para diferentes tipos de enterotoxinas.
Métodos moleculares
Técnicas como PCR permitem a detecção de genes codificadores de enterotoxinas. Embora não confirmem a presença da toxina ativa, indicam o potencial toxigênico da cepa.
Métodos avançados
Tecnologias mais recentes incluem:
Cromatografia líquida acoplada à espectrometria de massas (LC-MS/MS)
Biossensores baseados em anticorpos ou aptâmeros
Essas abordagens oferecem alta precisão, mas ainda são limitadas por custo e complexidade operacional.
Normas e protocolos
Diversos métodos são padronizados por organismos internacionais, como:
ISO 19020 (detecção de enterotoxinas estafilocócicas)
AOAC Official Methods
FDA BAM (Bacteriological Analytical Manual)
Limitações
Apesar dos avanços, ainda existem desafios:
Interferência de matriz alimentar
Limites de detecção variáveis
Necessidade de validação para diferentes alimentos
Considerações Finais e Perspectivas Futuras
As enterotoxinas estafilocócicas representam um dos exemplos mais claros de como a segurança alimentar não depende apenas da eliminação de microrganismos, mas do controle rigoroso de todo o processo produtivo. Sua resistência térmica desafia práticas tradicionais baseadas exclusivamente no cozimento, exigindo uma abordagem preventiva e sistêmica.
Do ponto de vista científico, o estudo dessas toxinas continua evoluindo, especialmente no que se refere à compreensão de sua estrutura, mecanismos de ação e variabilidade genética. No campo tecnológico, há um movimento crescente em direção ao desenvolvimento de métodos analíticos mais rápidos, sensíveis e aplicáveis em tempo real.
Para instituições e indústrias, a adoção de boas práticas de fabricação, aliada a sistemas robustos de monitoramento, é essencial para mitigar riscos. Investimentos em treinamento de manipuladores, controle de processos e rastreabilidade são medidas estratégicas que vão além da conformidade regulatória, contribuindo para a proteção da saúde pública.
Em perspectiva futura, espera-se que avanços em biotecnologia e biossensores permitam a detecção precoce de enterotoxinas diretamente nas linhas de produção, reduzindo significativamente a ocorrência de surtos. Paralelamente, a integração entre ciência, regulação e indústria será determinante para enfrentar os desafios impostos por esse agente persistente e altamente adaptável.
Em síntese, compreender como surgem as enterotoxinas estafilocócicas e por que permanecem perigosas mesmo após o cozimento é fundamental para qualquer estratégia moderna de segurança alimentar — uma área em constante evolução, que exige rigor técnico, vigilância contínua e inovação.
A Importância de Escolher a Polaris Análises
Com anos de experiência no mercado, a Polaris Análises possui um histórico comprovado de sucesso em análises laboratoriais.
Empresas do setor alimentício, indústrias farmacêuticas, laboratórios e outros segmentos confiam na Polaris Análises para garantir a segurança e qualidade da água utilizada em suas atividades.
Evitar riscos de contaminação é um compromisso com a saúde de seus clientes e com a longevidade do seu negócio. Investir em análises periódicas é um diferencial que fortalece sua reputação e evita prejuízos futuros.
Para saber mais sobre os serviços da Polaris Análises - Análises de Ar, Água, Alimentos, Swab e Efluentes ligue para (11) 91776-7012 (WhatsApp) ou clique aqui e solicite seu orçamento.
❓ FAQs – Perguntas Frequentes
O que são enterotoxinas estafilocócicas?
As enterotoxinas estafilocócicas são proteínas produzidas por algumas cepas de Staphylococcus aureus durante seu crescimento em alimentos. Elas são responsáveis por quadros de intoxicação alimentar e possuem alta estabilidade, mantendo sua atividade mesmo após o cozimento.
Por que essas toxinas continuam perigosas mesmo após o aquecimento dos alimentos?
Diferentemente das bactérias, que podem ser eliminadas pelo calor, as enterotoxinas são termoestáveis e resistem a temperaturas elevadas. Isso significa que, mesmo após um cozimento adequado, a toxina previamente formada pode permanecer ativa e causar intoxicação.
Em quais alimentos há maior risco de formação dessas toxinas?
Alimentos ricos em proteínas e altamente manipulados, como carnes cozidas, laticínios, recheios cremosos, saladas com maionese e produtos de confeitaria, são mais suscetíveis, especialmente quando permanecem por longos períodos em temperatura ambiente.
Como ocorre a produção de enterotoxinas nos alimentos?
A produção ocorre quando Staphylococcus aureus se multiplica em condições favoráveis, como temperaturas entre 20 °C e 40 °C, presença de nutrientes e tempo suficiente de exposição. A manipulação inadequada e a falha na refrigeração são fatores críticos nesse processo.
É possível detectar a presença dessas toxinas em análises laboratoriais?
Sim. A detecção pode ser feita por métodos imunológicos, como ELISA, além de técnicas moleculares e cromatográficas. Também é comum a análise indireta por meio da contagem de Staphylococcus coagulase positiva, que indica risco potencial de produção de toxinas.
Como prevenir a contaminação por enterotoxinas estafilocócicas?
A prevenção baseia-se no controle rigoroso do processo, incluindo boas práticas de manipulação, higiene dos manipuladores, controle de temperatura (refrigeração adequada), redução do tempo de exposição dos alimentos e implementação de sistemas como HACCP para monitoramento contínuo.
_edited.png)



Comentários